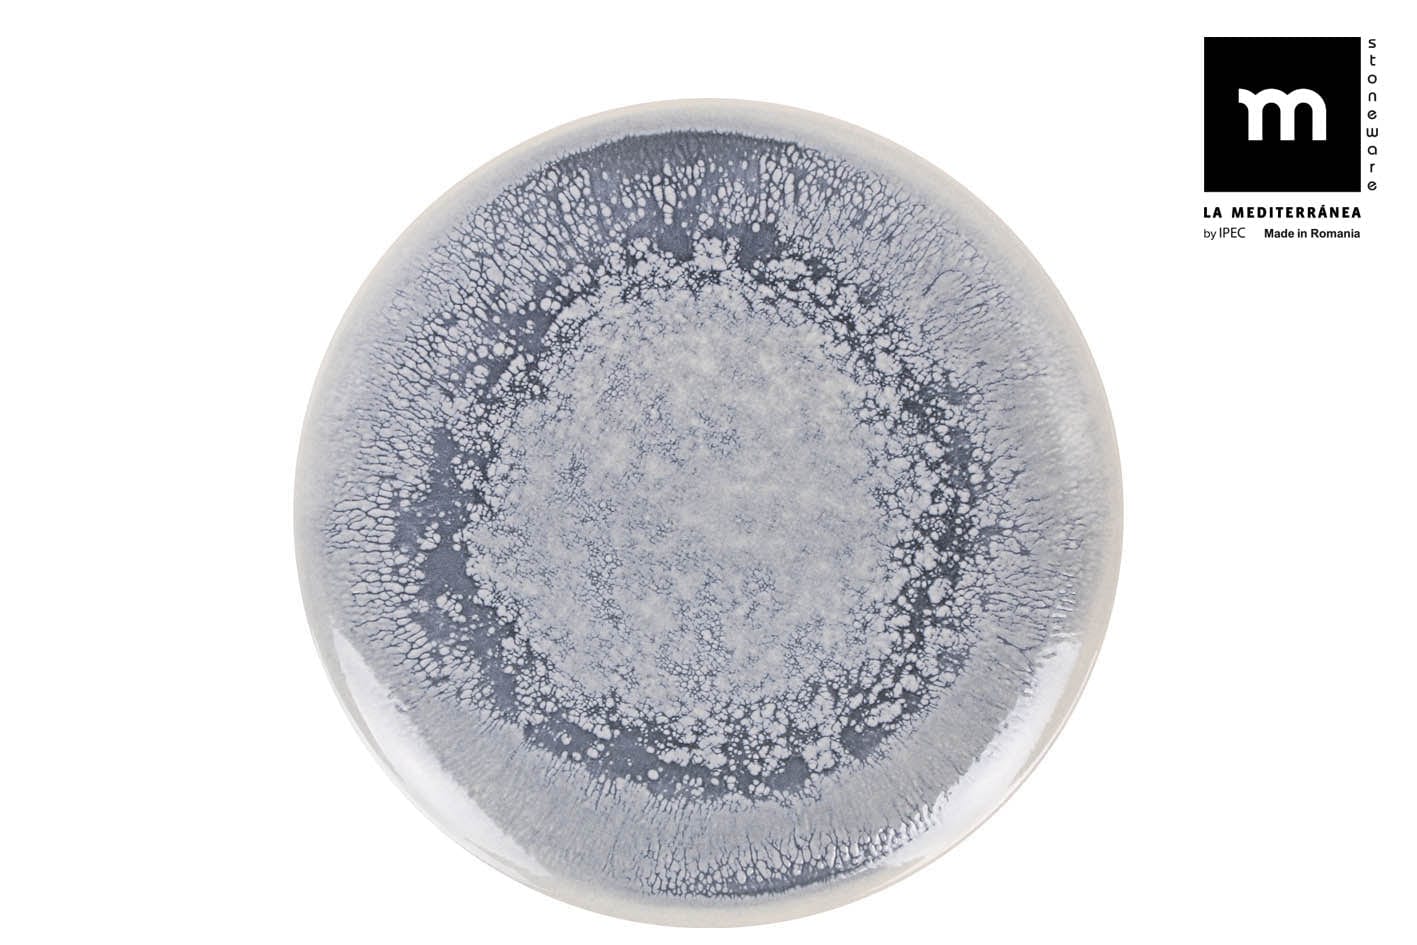
Platou servire din ceramica, Adhara Albastru, Ø32,5xH2,3 cm

Cart
Your cart is empty
Din păcate, nu am găsit niciun produs în coșul dumneavoastră.
Continua cumparaturile-60% la toate produsele cu codul: STOC60

60 30,40 lei
Preț final după aplicarea cuponului: STOC60
- Online cu card de debit sau de credit
- La livrare, cu cardul sau cash
compatibil microunde
Da
culoare
Albastru
diametru vesela
32.5 cm
disponibil in showroom
Nu
garantie
2 ani
greutate produs
1.06 kg
inaltime
2.3 cm
material produs
Ceramica
numar bucati
Intre 0 si 4 buc
perioada testare
14 zile
produs voluminos
Nu
tara brand
Spania
Culoare: Albastru
Material: Ceramica
Descriere:
Platoul Adhara este alegerea perfecta pentru acele cine in familie. Usor de folosit, util in orice bucatarie, sunt accesorii necesare si practice pentru orice cina reusita, fiind acel mic detaliu ce va face diferenta.
Dimensiuni:
Diametru: 32,5 cm
Inaltime: 2,3 cm
Detalii tehnice:
Produsul este realizat din ceramica.
Se poate spala in masina de spalat vase.
Se poate folosi in cuptorul cu microunde.
| Preț |
|---|
| SKU |
| Evaluare |
| Reducere |
| Etichete |
| Greutate |
| Stoc |
| scurta descriere |
Delivery demo text here that we can use to give customers more information
Description here
Your cart is empty
Din păcate, nu am găsit niciun produs în coșul dumneavoastră.
Continua cumparaturile